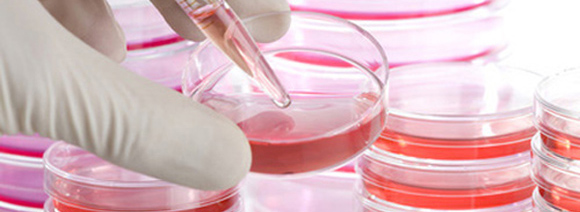

CO2培養箱的主要功能是為培養的細胞提供理想的生長環境。由于這些可能需要數月甚至數年的寶貴研究,因此培養箱的可靠性和穩定性至關重要。為避免培養箱故障并使珍貴的,通常不可替代的培養物風險zui小化,明智的做法是建立和維護CO2保溫箱預防性維護計劃。
如果培養箱停止運行,或者條件不能保持穩定,那么細胞死亡的風險就會大大增加,建立有效的CO2培養箱預防性維護計劃的一個很好的**步是咨詢制造商提供的信息。所有的CO2培養箱均配有全面的清單,詳細列出了常規維護和預防性維護步驟以及建議的執行頻率。
CO 2培養箱預防性維護計劃的目的 是確保zui佳的培養箱性能并避免污染。但是,如果有多個zui終用戶與培養箱進行交互,那么如果不遵循zui佳實踐,可以很容易地將其消除。這些措施包括使用適當的個人防護設備(PPE),遵守實驗室的良好操作規范,無菌技術以及基于實驗室生物安全水平的標準操作程序(SOP)。培訓應集中在zui大程度地降低細胞健康風險,例如,通過將門的開口保持在zui小程度來防止對生長室的破壞。記錄培養箱的使用和預防性維護活動可提醒您執行基本任務。
清潔CO2培養箱的頻率將根據多種因素而變化,例如實驗室環境的清潔度,使用培養箱的人數以及所培養細胞的類型。他說:“重要的是清潔培養箱的外部,以除去可能在門打開時進入生長室的污染物。” “在交通繁忙的實驗室中,每周可能經常需要這樣做一次,但是使用中性清潔劑或漂白劑在單一蒸餾水中的溶液很容易實現。”
每月使用無腐蝕性消毒劑(例如70%異丙醇或70%乙醇)清潔培養箱的內部一次至兩次。他指出:“應特別注意可能積聚污染物的接縫和縫隙。” “例如,門墊片是高污染區域。帶有一個連續內表面或一個可移動,可高壓滅菌的門墊的培養箱可以減少污染的風險。這應該每周執行一次,以zui大程度地減少污染物并防止細胞干燥。
現代培養箱具有多種功能,可降低污染的風險,其中zui重要的是閉環HEPA過濾器。未經HEPA過濾的培養箱更容易受到細菌,病毒,霉菌或支原體的污染
他說:“為了保持有效性,應根據預防性維護計劃定期更換過濾器。” 進氣口HEPA過濾器的平均壽命為三到六個月,并且由于長期使用而受到損害。我們還建議每隔五個儲氣罐或變色時更換供氣管線過濾器(CO 2和N 2),并每兩年更換空氣泵膠囊HEPA過濾器。”
為了zui大限度地延長CO2培養箱的使用壽命, 重要的是要考慮將其放置在實驗室中的什么位置。理想的位置是交通穩定,溫度低的區域,遠離強氣流,例如可能是污染物源的空調通風口。這將確保預防性維護計劃保持有效,并將有助于確保多年的一致,可靠的服務。